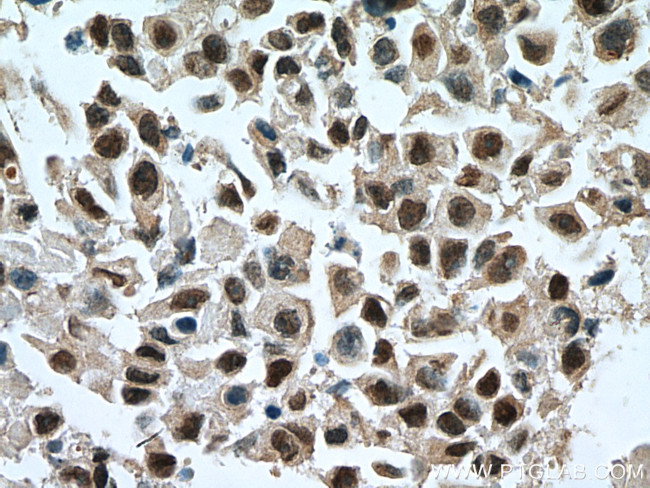
GATA3 Antibody in Immunohistochemistry (Paraffin) (IHC (P))

Search
Proteintech
GATA3 Polyclonal Antibody
{{$productOrderCtrl.translations['antibody.pdp.commerceCard.promotion.promotions']}}
{{$productOrderCtrl.translations['antibody.pdp.commerceCard.promotion.viewpromo']}}
{{$productOrderCtrl.translations['antibody.pdp.commerceCard.promotion.promocode']}}: {{promo.promoCode}} {{promo.promoTitle}} {{promo.promoDescription}}. {{$productOrderCtrl.translations['antibody.pdp.commerceCard.promotion.learnmore']}}
产品信息
10417-1-AP
种属反应
已发表种属
宿主/亚型
分类
类型
抗原
偶联物
形式
浓度
规格
纯化类型
保存液
内含物
保存条件
运输条件
产品详细信息
This is a rabbit polyclonal antibody raised against part of C-terminus of human GATA3.
Immunogen sequence: PYVPEYSSG LFPPSSLLGG SPTGFGCKSR PKARSSTGRE CVNCGATSTP LWRRDGTGHY LCNACGLYHK MNGQNRPLIK PKRRLSAARR AGTSCANCQT TTTTLWRRNA NGDPVCNACG LYYKLHNINR PLTMKKEGIQ TRNRKMSSKS KKCKKVHDSL EDFPKNSSFN PAALSRHMSS LSHISPFSHS SHMLTTPTPM HPPSSLSFGP HHPSSMVTAM (224-442 aa encoded by BC003070)
靶标信息
The genes for all 4 subunits of the T-cell antigen receptor (alpha, beta, gamma and delta) are controlled by distinct enhancers and their enhancer-binding proteins. Marine and Winoto (1991) identified a common TCR regulatory element by demonstrating binding of the enhancer-binding protein GATA3 to the enhancer elements of all 4 TCR genes. GATA3 had been shown in the chicken to be an enhancer-binding protein containing a zinc finger domain. GATA3 mRNA was demonstrated by Northern blot analysis in T cells but not in B cells or macrophages. GATA3 is abundantly expressed in the T-lymphocyte lineage and is thought to participate in T-cell receptor gene activation through binding to enhancers. Labastie et al. (1994) cloned the human gene and the 5-prime end of the mouse gene. The human gene comprises 6 exons distributed over 17 kb of DNA. Its 2 zinc fingers are encoded by 2 separate exons highly conserved with those of GATA1, but no other structural homologies between the 2 genes could be found.
仅用于科研。不用于诊断过程。未经明确授权不得转售。
生物信息学
蛋白别名: GATA binding protein-3; GATA-3; GATA-binding factor 3; MGC2346; MGC5199; MGC5445; Trans-acting T-cell-specific transcription factor GATA-3; Transacting T-cell-specific transcription factor GATA-3; unnamed protein product
基因别名: GATA3; HDR; HDRS
UniProt ID: (Human) P23771
Entrez Gene ID: (Human) 2625